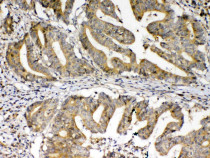

ARG40599
anti-FZD3 / Frizzled 3 antibody
anti-FZD3 / Frizzled 3 antibody for IHC-Formalin-fixed paraffin-embedded sections,Western blot and Human,Mouse,Rat
Overview
| Product Description | Rabbit Polyclonal antibody recognizes FZD3 / Frizzled 3 |
|---|---|
| Tested Reactivity | Hu, Ms, Rat |
| Tested Application | IHC-P, WB |
| Host | Rabbit |
| Clonality | Polyclonal |
| Isotype | IgG |
| Target Name | FZD3 / Frizzled 3 |
| Antigen Species | Human |
| Immunogen | Synthetic peptide corresponding to a sequence of Human FZD3 (MPNLLNHYDQQTAALAMEPFHPMVNLDCSRDFRPFL). |
| Conjugation | Un-conjugated |
| Alternate Names | Fz-3; Frizzled-3; hFz3 |
Application Instructions
| Application Suggestion |
|
||||||
|---|---|---|---|---|---|---|---|
| Application Note | IHC-P: Antigen Retrieval: Heat mediation was performed in Citrate buffer (pH 6.0, epitope retrieval solution) for 20 min. * The dilutions indicate recommended starting dilutions and the optimal dilutions or concentrations should be determined by the scientist. |
||||||
| Observed Size | ~ 76 kDa |
Properties
| Form | Liquid |
|---|---|
| Purification | Affinity purification with immunogen. |
| Buffer | 0.2% Na2HPO4, 0.9% NaCl, 0.05% Sodium azide and 4% Trehalose. |
| Preservative | 0.05% Sodium azide |
| Stabilizer | 4% Trehalose |
| Concentration | 0.5 mg/ml |
| Storage Instruction | For continuous use, store undiluted antibody at 2-8°C for up to a week. For long-term storage, aliquot and store at -20°C or below. Storage in frost free freezers is not recommended. Avoid repeated freeze/thaw cycles. Suggest spin the vial prior to opening. The antibody solution should be gently mixed before use. |
| Note | For laboratory research only, not for drug, diagnostic or other use. |
Bioinformation
| Database Links | |
|---|---|
| Gene Symbol | FZD3 |
| Gene Full Name | frizzled class receptor 3 |
| Background | This gene is a member of the frizzled gene family. Members of this family encode seven-transmembrane domain proteins that are receptors for the wingless type MMTV integration site family of signaling proteins. Most frizzled receptors are coupled to the beta-catenin canonical signaling pathway. The function of this protein is unknown, although it may play a role in mammalian hair follicle development. Alternative splicing results in multiple transcript variants. This gene is a susceptibility locus for schizophrenia. [provided by RefSeq, Dec 2010] |
| Function | Receptor for Wnt proteins. Most of frizzled receptors are coupled to the beta-catenin canonical signaling pathway, which leads to the activation of disheveled proteins, inhibition of GSK-3 kinase, nuclear accumulation of beta-catenin and activation of Wnt target genes. A second signaling pathway involving PKC and calcium fluxes has been seen for some family members, but it is not yet clear if it represents a distinct pathway or if it can be integrated in the canonical pathway, as PKC seems to be required for Wnt-mediated inactivation of GSK-3 kinase. Both pathways seem to involve interactions with G-proteins. Activation by Wnt5A stimulates PKC activity via a G-protein-dependent mechanism. Involved in transduction and intercellular transmission of polarity information during tissue morphogenesis and/or in differentiated tissues. Plays a role in controlling early axon growth and guidance processes necessary for the formation of a subset of central and peripheral major fiber tracts. Required for the development of major fiber tracts in the central nervous system, including: the anterior commissure, the corpus callosum, the thalamocortical, corticothalamic and nigrostriatal tracts, the corticospinal tract, the fasciculus retroflexus, the mammillothalamic tract, the medial lemniscus, and ascending fiber tracts from the spinal cord to the brain. In the peripheral nervous system, controls axon growth in distinct populations of cranial and spinal motor neurons, including the facial branchimotor nerve, the hypoglossal nerve, the phrenic nerve, and motor nerves innervating dorsal limbs. Involved in the migration of cranial neural crest cells. May also be implicated in the transmission of sensory information from the trunk and limbs to the brain. Controls commissural sensory axons guidance after midline crossing along the anterior-posterior axis in the developing spinal cord in a Wnt-dependent signaling pathway. Together with FZD6, is involved in the neural tube closure and plays a role in the regulation of the establishment of planar cell polarity (PCP), particularly in the orientation of asymmetric bundles of stereocilia on the apical faces of a subset of auditory and vestibular sensory cells located in the inner ear. Promotes neurogenesis by maintaining sympathetic neuroblasts within the cell cycle in a beta-catenin-dependent manner (By similarity). [UniProt] |
| Cellular Localization | Membrane; Multi-pass membrane protein. Cell membrane; Multi-pass membrane protein. Cell surface. [UniProt] |
| Calculated MW | 76 kDa |
| PTM | Ubiquitinated by ZNRF3, leading to its degradation by the proteasome. [UniProt] |
Images (5) Click the Picture to Zoom In
-
ARG40599 anti-FZD3 / Frizzled 3 antibody IHC-P image
Immunohistochemistry: Paraffin-embedded Human colon cancer tissue. Antigen Retrieval: Heat mediation was performed in Citrate buffer (pH 6.0, epitope retrieval solution) for 20 min. The tissue section was blocked with 10% goat serum. The tissue section was then stained with ARG40599 anti-FZD3 / Frizzled 3 antibody at 1 ug/ml, overnight at 4°C.
-
ARG40599 anti-FZD3 / Frizzled 3 antibody WB image
Western blot: 50 ug of samples under reducing conditions. SK-OV-3 and Jurkat cell lysates stained with ARG40599 anti-FZD3 / Frizzled 3 antibody at 0.5 ug/ml, overnight at 4°C.
-
ARG40599 anti-FZD3 / Frizzled 3 antibody IHC-P image
Immunohistochemistry: Paraffin-embedded Human mammary cancer tissue. Antigen Retrieval: Heat mediation was performed in Citrate buffer (pH 6.0, epitope retrieval solution) for 20 min. The tissue section was blocked with 10% goat serum. The tissue section was then stained with ARG40599 anti-FZD3 / Frizzled 3 antibody at 1 ug/ml, overnight at 4°C.
-
ARG40599 anti-FZD3 / Frizzled 3 antibody IHC-P image
Immunohistochemistry: Paraffin-embedded Mouse kidney tissue. Antigen Retrieval: Heat mediation was performed in Citrate buffer (pH 6.0, epitope retrieval solution) for 20 min. The tissue section was blocked with 10% goat serum. The tissue section was then stained with ARG40599 anti-FZD3 / Frizzled 3 antibody at 1 ug/ml, overnight at 4°C.
-
ARG40599 anti-FZD3 / Frizzled 3 antibody IHC-P image
Immunohistochemistry: Paraffin-embedded Rat kidney tissue. Antigen Retrieval: Heat mediation was performed in Citrate buffer (pH 6.0, epitope retrieval solution) for 20 min. The tissue section was blocked with 10% goat serum. The tissue section was then stained with ARG40599 anti-FZD3 / Frizzled 3 antibody at 1 ug/ml, overnight at 4°C.